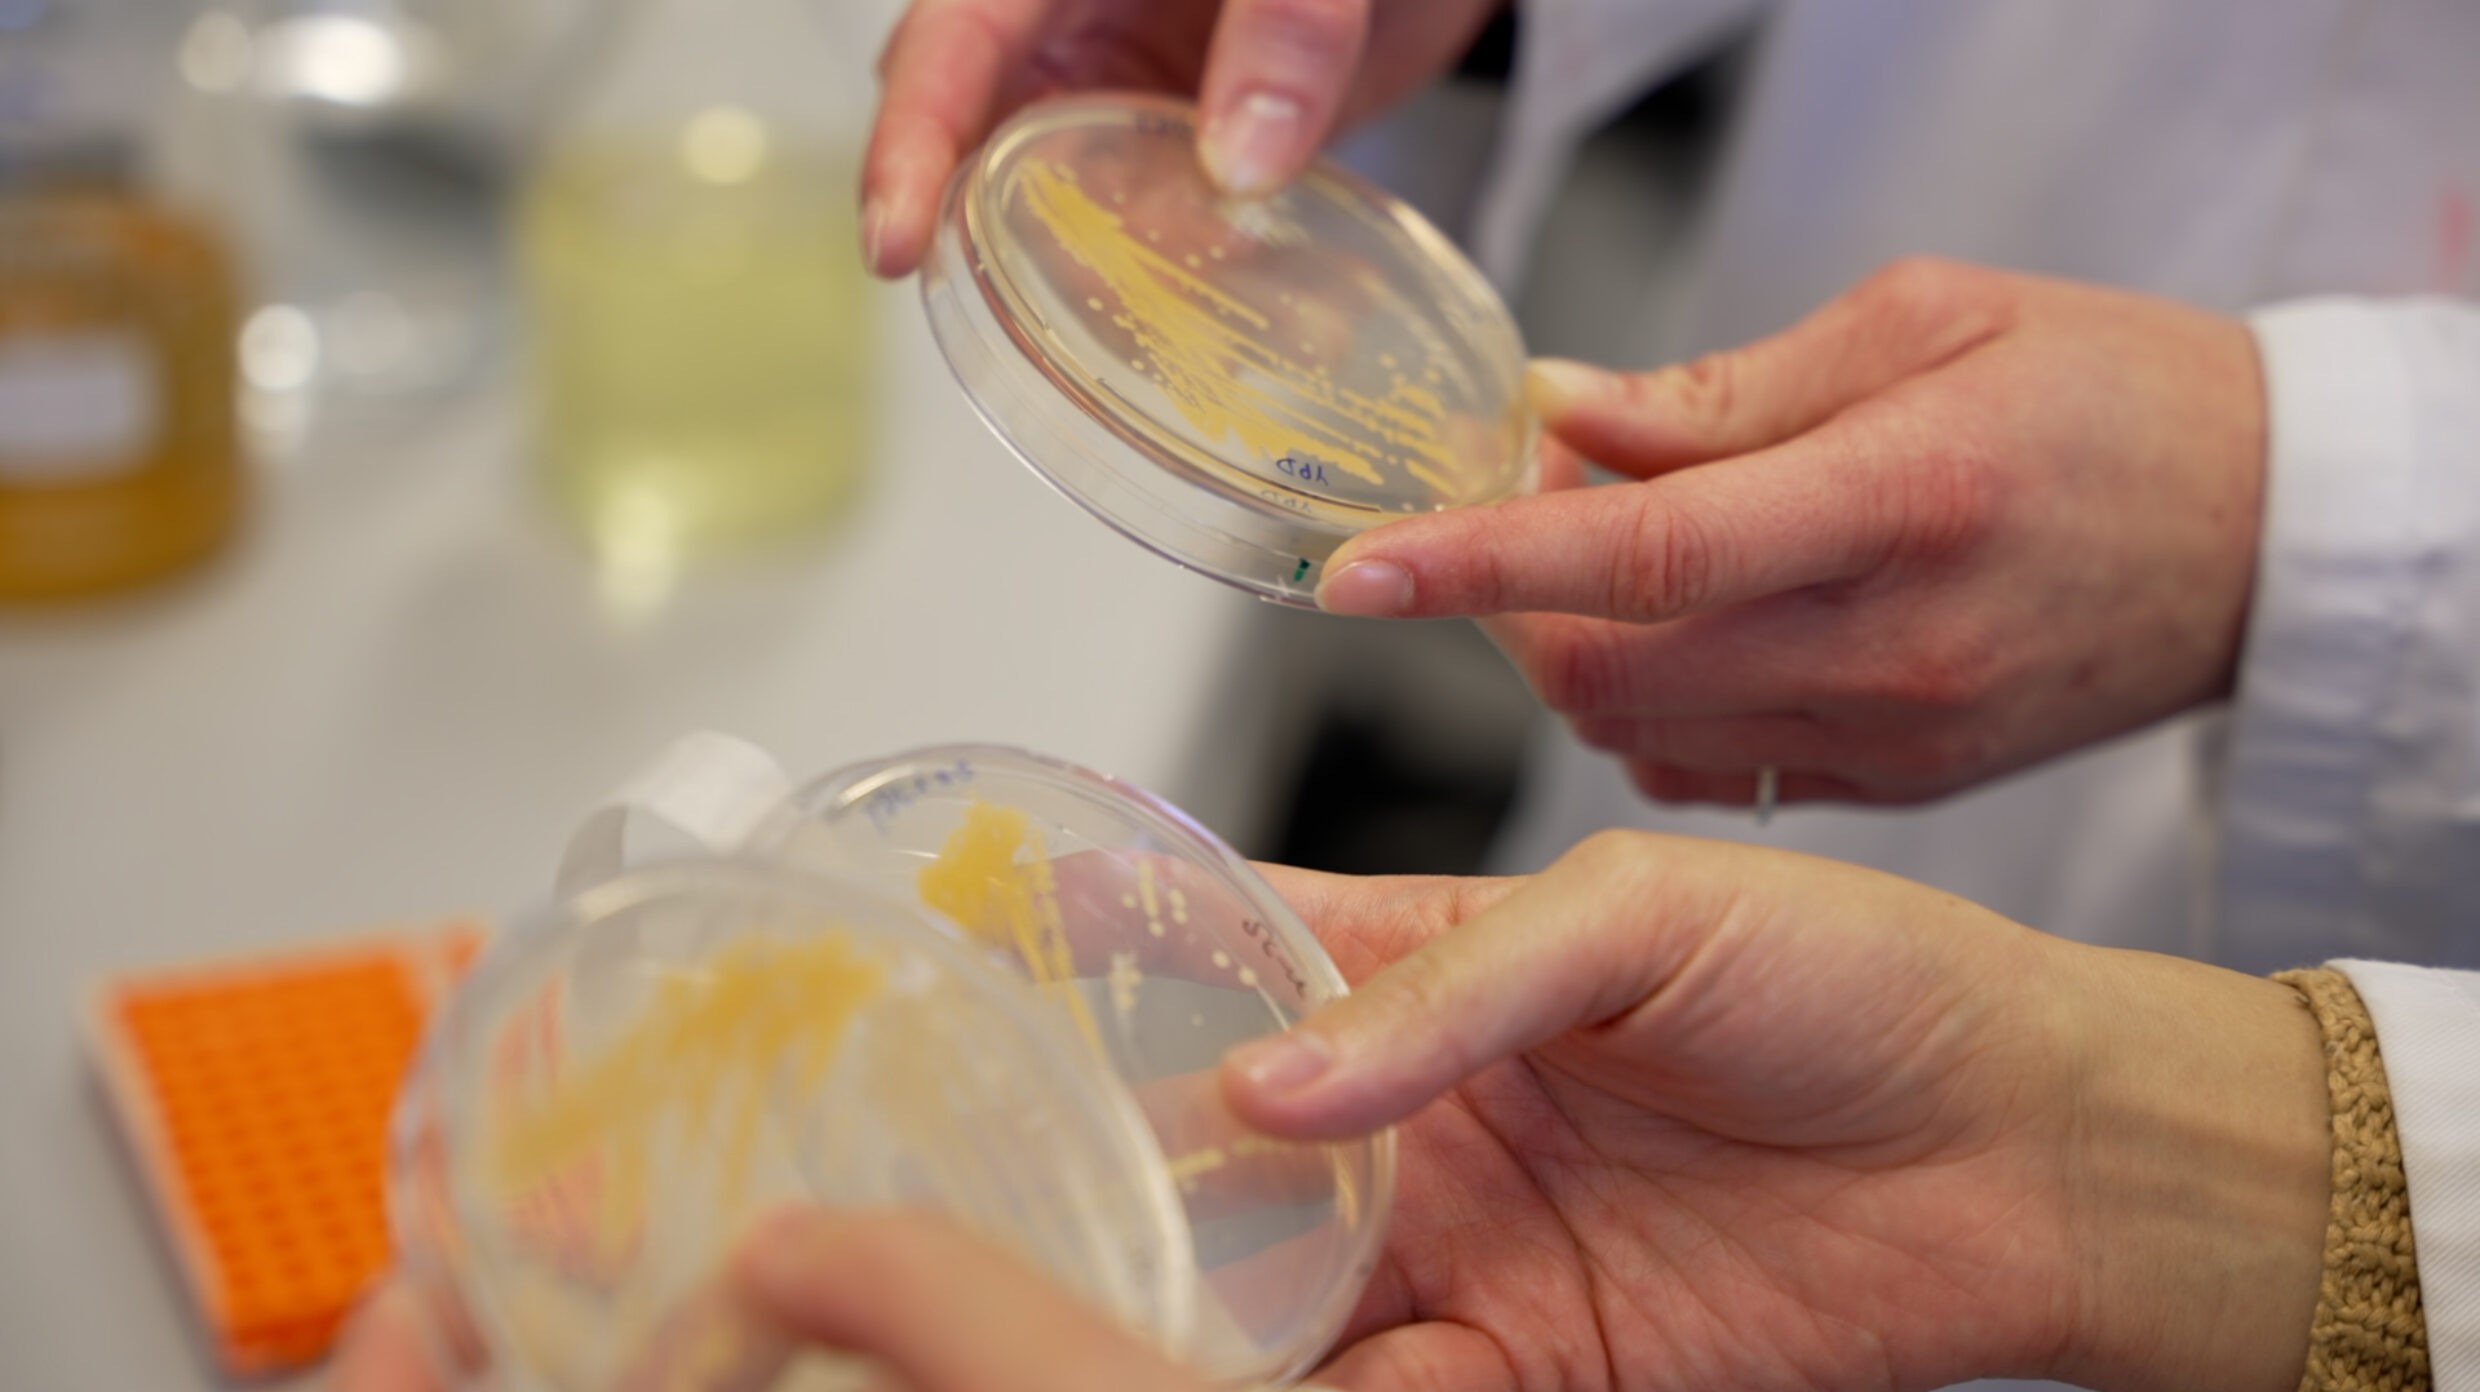

MerMADE
Entered program in 2025Unlocking the deep sea treasure chest

The deep sea harbors over 30,000 natural compounds, yet accessing them remains highly challenging. Current production methods often depend on inefficient, costly, and labor-intensive algae extraction processes.
MerMADE is pioneering a fermentation-based production platform to address these limitations. Our goal is to create a scalable, sustainable, cost-effective solution for producing natural marine compounds, unlocking their potential for applications across the nutraceutical, cosmetic, and food industries.
This project is supported by Spin-outs Denmark, a unique program that invests in researchers who create more impact by starting research-based companies.